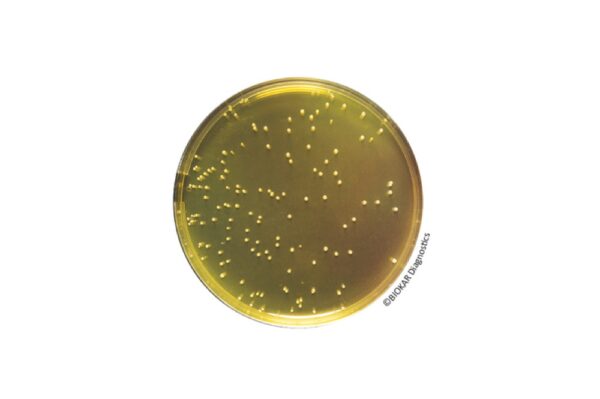
Image_TEC_INS_Biokar_ReadyToUse_02_1000x665_JPG Image_TEC_INS_Biokar_ReadyToUse_02_1000x665_JPG

Biokar – Microbiology – Ready-to-use culture media
Biokar Diagnostics is the microbiology division of the Solabia group, dedicated to the development, production and selling of culture media, supplements and detection kits for microbiology laboratories.
Available Models

| Model name | Description | Packaging |
|---|---|---|
| Bacillus cereus Agar(Acc. To Mossel) | Bacillus cereus Agar is used for the detection and enumeration of spores and vegetative cells of Bacillus cereus in food products. The typical composition corresponds to the MYP agar (mannitol, egg yolk, polymyxin agar) described in the standards NF EN ISO 7932 and NF EN ISO 21871. | BK116HA – 500 g bottle |
| BCP Dextrose Agar | BCP Dextrose Tryptone Agar (also known as BCP Glucose agar) is used to enumerate mesophilic and thermophilic aerobic bacterial spores (especially Bacillus stearothermophilus, responsible for flat sour) in raw materials and in ingredients used in canning non-acid products (pH > 4,5). It is also used in surface samples and canning process water. | BK042HA – 500 g bottle |
| COMPASS® Bacillus cereus Agar / COMPASS® Bacillus Plus Agar | COMPASS® Bacillus cereus Agar is a solid medium used for the detection and the enumeration of spores and vegetative forms of presumptive species belonging to the group Bacillus cereus in products destined for human and animal consumption. COMPASS® Bacillus Plus Agar is obtaine by adding nutritive supplement to COMPASS® Bacillus cereus Agar. This media permit to reduce the incubation time to 21h and it allows too the recovery of all strains of the Bacillus cereus group, including Bacillus cytotoxicus. | BK189HA – 500 g bottle |

| Model name | Description | Packaging |
|---|---|---|
| Thioglycollate Medium with Resazurin | Thioglycollate Medium with Resazurin is used for sterility tests of biological products and for the culture of aerobic, anaerobic and microaerophilic bacteria. This medium is also used for the confirmation of Clostridium perfringens in food products. | BK017HA – 500 g bottle |
| Tryptone Sulfite Cycloserine (TSC) Agar | Tryptone Sulfite Cycloserine Agar was described by Harmon for the selective isolation and enumeration of Clostridium perfringens in water and food samples. The medium was recommended for the enumeration of sulfur-reducing anaerobes from foods of animal origin. | BK031HA – 500 g bottle |

| Model name | Description | Packaging |
|---|---|---|
| Brilliant Green Bile Broth (BGBB) | Brilliant Green Bile Broth (BGBB) is used for the confirmation of coliforms and thermotolerant coliforms in food products, water used for watering food products and for effluent / run-off water testing. It can also be used as an enumeration media for coliforms in frozen dairy and ice cream products. | BK002HA – 500 g bottle |
| COMPASS® cc Agar | COMPASS® cc Agar allows the direct enumeration of Escherichia coli and coliforms in water by membrane filtration in 24 hours, without the typical confirmation tests as oxidase detection or indole production from tryptophan. | BK210HA – 500 g bottle |
| Laurylsulfate-Tryptose broth | Laurylsulfate-Tryptose broth is a selective enrichment media used for the detection and enumeration of Escherichia coli and coliforms in water and food products. | BK010HA – 500 g bottle |
| Tergitol 7 Agar | Tergitol 7 Agar is used for the enumeration of Escherichia coli and coliform bacteria in water, notably potable water, through the membrane filtration method. This media is also used for testing swimming pool water. | BK123HA – 500 g bottle |
| Violet Red Bile (VRBL) Agar | Violet Red Bile Agar (VRBL) is a selective medium used for the detection and enumeration of coliform and thermotolerant coliforms food products. | BK152HA – 500 g bottle BK152GC – 500 g drum |

| Model name | Description | Packaging |
|---|---|---|
| Chromogenic Cronobacter Isolation (CCI) Agar | CCI Agar is used for the detection of Cronobacter spp. in food products and ingredients intended for human consumption and the feeding of animals. It is also used for the control of production environmental samples. CCI Agar is used in particular for the detection of Cronobacter sakazakii and spp. in milk powder, dehydrated products and their components found in infant foods. | BK200HA – 500 g |
| COMPASS® Enterobacter Sakazakii Agar | The COMPASS® Enterobacter sakazakii Agar is used for the detection of Cronobacter sakazakii and spp. in milk powder, dehydrated products and their components found in infant foods. | BK188HA – 500 g bottle |
| Cronobacter Screening Broth (CSB) | Cronobacter Screening broth is a selective enrichment media used for the detection of Cronobacter spp. in food products and ingredients intended for human consumption and the feeding of animals. It is also used for the control of production environmental samples. | BM15508 – 50 tubes of 10 mL |
| CSD method | The CSD method allows the rapid detection of Cronobacter spp in human food products (especially milk powders and infant ingredients) and products from the production environment. At the end of an enrichment phase with Salmonella Enrichment + CSD supplement, a subculture is carried out on CCI agar. The characteristic colonies will be confirmed. | BK194HA – 500 g bottle |
| Modified Laurylsulfate-Tryptose Vancomycin broth (mLST/V) | Modified Laurylsulfate-Tryptose Vancomycin broth (mLST/V) is a selective enrichment medium used for the detection of Cronobacter sakazakii in milk and milk products. | BK190HA – 500 g bottle |

| Model name | Description | Packaging |
|---|---|---|
| Dipotassium Hydrogenphosphate Solution | Dipotassium hydrogenphosphate solution is a diluent used to prepare dispersion solutions for the microbiological control of cheese, roller-dried milk, fermented milk, caseinates, dried acid whey, and sour cream. | BM19308 – 2 flexible bags of 5 L |
| Eugon LT 100 Broth | Eugon LT 100 broth is used as a neutralizing diluent and as an enrichment media for microorganisms in cosmetic products with and without preservatives. The typical formula corresponds to that defined in all the cosmetic standards cited as references in the bibliography. | BK137HA – 500 g bottle |
| Eugon LT SUP Broth | Eugon LT SUP broth is used as a neutralizing diluent and as an enrichment medium for mesophilic aerobic bacteria in cosmetic products with and without preservatives. This broth substitutes the Eugon LT 100 broth, cited in the reference standards related to the microbiology of cosmetic products. | BM22208 – 10 vials of 100 mL BM21908 – 50 tubes of 9 mL BM22408 – 50 tubes of 9 mL+ glass balls |
| Peptone Water 0.1% | Peptone Water 0,1 % is one of the general use diluents used in the preparation of stock solutions of milk and dairy products according to ISO 6887-5 and for water analysis according to the standard NF EN ISO 8199. | BM16408 – 2 flexible bags of 5 L |
| Sterile Distilled Water | Sterile distilled water is a diluent used for the rehydration of freeze-dried supplements. | BM11508 – 50 tubes of 18 mL BM19408 – 10 vials of 90 mL |
| Synthetic Sea Salt | Synthetic sea salt is used as a diluent for the detection and the enumeration of Escherichia coli and enterococci in bathing water and surface water in microplates. | BM08808 – 50 tubes 18 mL |
| Tryptone-Salt Broth | Tryptone-Salt Broth is a diluent used to prepare stock solutions of food and dairy products as well as cosmetics in preparation for microbiological analysis. It is also used to prepare serial dilutions. | BK014HA – 500 g bottle |

| Model name | Description | Packaging |
|---|---|---|
| Glucose Agar | Glucose agar allows the demonstration of glucose fermentation (with or without gas production) as an identification test for Enterobacteriaceae or Pseudomonas spp. | BM09908 – 50 tubes of 10 mL |
| MacConkey agar | MacConkey agar is a selective medium for the isolation of enterobacteria in water, food, pharmaceutical products and biological samples of animal origin and in cosmetic products. | BK050HA – 500 g bottle |
| OF Glucose Agar | The OF Glucose agar allows the demonstration of glucose fermentation as an identification test for Enterobacteriaceae in the context of the following standards : NF EN ISO 21528-1 and NF EN ISO 21528-2 for the detection and enumeration of Enterobacteriaceae. | 50 tubes of 10 mL – BM19708 |
| VRBG Agar | Violet Red Bile Glucose Agar containing crystal violet and neutral red (VRBG Agar) was used by Mossel for the detection and enumeration of enterobacteria in dairy products, meat, prepared pork products and other food products. The media can also be used for the detection of Gram negative, bile resistant bacteria during the microbiological control of non-sterile products. | BK011HA – 500 g bottle BK011GC – 5 kg drum |

| Model name | Description | Packaging |
|---|---|---|
| BEA agar (Bile, Esculin, Azide) | Bile Esculin Azide Agar (BEA agar) is a selective medium used to isolate and enumerate enterococci in food and pharmaceutical products. It is also used for the enumeration of enterococci animal feed. | BK158HA – 500 g bottle |
| COMPASS® Enterococcus Agar | COMPASS® Enterococcus Agar is a selective media used for the enumeration of enterococci in food and water. | BK183HA – 500 g bottle |
| Slanetz and Bartley Agar | Slanetz and Bartley Agar is a selective medium used for the enumeration of intestinal enterococci in drinking water, beverages, waste water, swimming pool water and various biological products of animal origin, by the membrane filtration method. | BK037HA – 500 g bottle |

| Model name | Description | Packaging |
|---|---|---|
| Tryptone-Bile-X-Glucuronate (TBX) Agar (CCA) | TBX Agar is a selective medium for the enumeration of β-D-glucuronidase-positive Escherichia coli in food products. The result is obtained directly by counting characteristic colonies after only 24 hours of incubation and no confirmation step is required. | BM06908 – 10 vials of 100 mL BM17108 – 10 vials of 200 mL |

| Model name | Description | Packaging |
|---|---|---|
| BCYE Agar with cysteine & BCYE Agar without cysteine | The two confirmation agars for Legionella, BCYE and BCYE without cysteine are destined for the confirmation of colonies obtained on GVPC agar, which itself is used for the enumeration and isolation of Legionella species in water and in other samples susceptible of harboring the bacteria. | BCYE agar with cysteine pre-poured medium: BM07208 – 20 Petri plates Ø 90 mm BCYE agar without cysteine pre-poured medium: BM07308 – 20 Petri plates Ø 90 mm |
| GVPC Agar for Legionella | GVPC for Legionella is used for the enumeration, isolation and culture of Legionella species in clean water (hot water production, swimming pools…) and in dirty water (industrial water, cooling towers…). | BM07108 – 20 Petri plates Ø 90 mm |

| Model name | Description | Packaging |
|---|---|---|
| COMPASS® Listeria constitutes | COMPASS® Listeria constitutes a method constitutes a method for the detection of Listeria monocytogenes and of Listeria spp, and a method for the enumeration of Listeria monocytogenes in food products, and in environmental samples even heavily contaminated. | BK192HA – 500 g bottle |
| CONFIRM’ L. mono Agar® | CONFIRM’ L. mono Agar® is a solid culture media designed for the confirmation of the genus & species Listeria monocytogenes, isolated from a single characteristic colony from COMPASS® Listeria Agar, within the context of the detection method (certified AFNOR Certification, under the reference number BKR 23/2-11/02 and enumeration methods (certified AFAQ AFNOR Certification under the reference number BKR 23/05-12/07). | BM13908 – 10 Petri plates Ø 90 mm |
| CONFIRM’ L. mono broth® | The CONFIRM’ L. mono broth® is a liquid media destined for the confirmation of the genus & species Listeria monocytogenes, isolated from a single characteristic colony from COMPASS® Listeria Agar, within the context of the alternative methods for the detection and enumeration of Listeria monocytogenes certified NF VALIDATION. | BM16208 – 18 tubes of 1 mL |
| Fraser Broth | Fraser broth is used for the selective secondary enrichment of Listeria monocytogenes and other Listeria in food products | BK115HA – 500 g bottle |
| Half Fraser Broth | Half Fraser broth is used for the selective and differential (primary enrichment broth) enrichment of Listeria monocytogenes and of Listeria spp in food products, according to the Standard NF EN ISO 11290-1. | BM01608 – 10 vials of 225 mL BM13308 – 3 flexible bags of 3 L BM13408 – 2 flexible bags of 5 L BM18808 – 40 flexible bags of 5 L (carton) |
| PALCAM Agar | PALCAM Agar is a selective medium used for the differentiation and isolation of Listeria monocytogenes and other Listeria, from milk and cheese, as well as in other food products, even highly contaminated. | BK145HA – 500 g bottle |

| Model name | Description | Packaging |
|---|---|---|
| Acetamide broth | Acetamide broth constitutes one of the confirmation media (in association with King B agar) used in water analysis for the detection and enumeration of Pseudomonas aeruginosa. It is generally accepted that natural mineral water, spring water and bottled water should not contain this opportunistic pathogen. For reasons of public health, other types of water such as swimming pools and potable water may also be examined for the presence of Pseudomonas aeruginosa. | BM09508 – 7 tubes of 5 mL |
| CFC Agar | CFC Agar is a selective medium for the enumeration of Pseudomonas spp. that frequently contaminates meats and poultry-based products during their cold storage. The typical composition responds to the standard NF EN ISO 13720, for the enumeration of presumptive Pseudomonas in meats and meat-based products. | BK118HA – 500 g bottle |
| CN Agar for Pseudomonas | CN Agar for Pseudomonas is a selective medium for the isolation and enumeration of Pseudomonas aeruginosa in bottled water, swimming pools and water destined for human consumption. | BK165HA – 500 g bottle |
| King B Agar | King B agar allows the production of fluoresceine (or pyoverdin), a yellow-green pigment that fluoresces under ultraviolet light in certain strains of Pseudomonas. The medium is used primarily in water analysis for the detection and differentiation of Pseudomonas aeruginosa, which produce the characteristic pigment while other species of Pseudomonas do not. | BM10508 – 7 tubes of 7 mL |
| Penicillin and Pimaricin Agar (PPA) | Penicillin and Pimaricin Agar (PPA) is a selective medium for the enumeration of pigmented and non-pigmented psychrotophic Pseudomonas in milk, milk products and in dairy environment samples. | BM15608 – 20 Petri plates Ø 90 mm |
| RHAPSODY Agar® | RHAPSODY Agar® is a selective medium used for the enumeration of Pseudomonas spp. in food products and environmental samples. | BM16708 – 20 Petri plates Ø 90 mm |

| Model name | Description | Packaging |
|---|---|---|
| COMPASS® Salmonella Agar | COMPASS® Salmonella Agar is a selective media allowing the isolation and differentiation of bacteria belonging to the genus Salmonella. It can be used as the second media in all normalized and validated methods for the detection of Salmonella. COMPASS® Salmonella Agar is also used in the context of the rapid alternative method for the detection of Salmonella (SESAME Salmonella TEST®). | BM06608 – 20 Petri plates Ø 90 mm |
| IRIS Salmonella® | IRIS Salmonella® is an alternative research method of Salmonellae in human food and feeds, and environmental sample (except primary production samples). Studies performed on IRIS Salmonella® Agar show a high specificity for the detection of Salmonellae including atypical species and serovars, which is a source of confusion on other medium. | IRIS Salmonella® |
| MSRV Medium | Modified Semi-Solid Rappaport-Vassiliadis Agar (MSRV) is a selective medium historically used for the isolation of Salmonella in chocolate and other food products. It is also widely used in animal health: in particular with mammals, poultry and in animal production facilities. It is also recommended for us in the detection of motile Salmonellae in animal fecal matter and in environmental samples in the context of primary animal production. | BK191HA – 500 g bottle |
| Rappaport-Vassiliadis Soja (RVS) Broth | Rappaport-Vassiliadis Soja Broth is used for the selective enrichment of Salmonella in milk, dairy products, other food products, water and in environmental samples. | BK148HA – 500 g bottle |
| Salmonella Enrichment | Salmonella Enrichment is a special formulation of Buffered Peptone Water that has been created and controlled for optimal detection of Salmonella in food products and feed. | BK194HA – 500 g bottle BK194CG – 5 kg drum |
| Salmonella Enrichment double-strength buffered | Salmonella Enrichment double-strength buffered is a special formulation of Double-strength Buffered Peptone Water that has been created and controlled for optimal detection of Salmonella in food products and feed with an acid pH (lower than 4,5). | BM20008 – 2 flexible bags 5 L |
| SESAME Salmonella TEST® | SESAME Salmonella TEST® represents an alternative method for the detection of Salmonella in human and animal products, as well as environmental samples (with the exception of those from animal production). This method is destined to the detection of motile Salmonella, and is not adapted to non-motile Salmonella (non-motile strains or that have lost their mobility. | BK195HA – 500 g bottle |
| Tryptophan Broth | Tryptophan broth allows the culture of microorganisms presenting no particular growth requirements. The media is used to perform the indole production test, used notably in the confirmation of Escherichia coli, Shigella and Salmonella. | BK163HA – 500 g bottle |
| XLT4 (Xylose-Lysine-Tergitol 4) Agar | XLT4 (Xylose-Lysine-Tergitol 4) Agar is a selective isolation medium for the detection of Salmonella, except for Salmonella Typhi and Paratyphi. It can be used as the second media of choice in the normalized methods of Salmonella detection in food microbiology. It is also used as media of choice in animal health for Salmonella detection. | BK156HA – 500 g bottle |

| Model name | Description | Packaging |
|---|---|---|
| Baird-Parker Agar with Egg Yolk Tellurite | Baird-Parker Agar with egg yolk and potassium tellurite is a selective medium for the detection and enumeration of Staphylococcus aureus in animal origin biological samples, pharmaceutical products, cosmetics, foods and water. | BK055HA – 500 g bottle BK055GC – 5 kg drum |
| Baird Parker RPF Agar | Baird Parker RPF (RPF = Rabbit Plasma Fibrinogen) Agar is used for the direct detection and enumeration of coagulase positive staphylococci. The medium has the advantage of considerably reducing the number of confirmation tests for the presence of coagulase positive staphylococci particularly when atypical colonies are observed on other selective media. | BK055HA – 500 g bottle BK055GC – 5 kg drum |
| EASY STAPH Agar | EASY STAPH is an alternative method for the enumeration of coagulase positive Staphylococci in food products, in animal feeds and in environmental samples. Devoid of the need for confirmation, the method allows count of pathogenic staphylococci in 22 hours instead of the usual 48 hours in the case of the standardized method NF EN ISO 6888-2. The media support the use of surface inoculation, in depth or by the Spiral method. | BM18708 – 20 Petri plates Ø 90 mm BM19008 – 120 Petri plates Ø 90 mm |
| Giolitti & Cantoni Broth with Tween 80 (Base) | Giolitti and Cantoni Broth with Tween 80 is a selective enrichment medium for the detection and enumeration (particularly in low numbers) of coagulase positive staphylococci in food products. | BK159HA – 500 g bottle |
| Mannitol Salt Agar | Mannitol Salt agar is used for the selective isolation, detection and enumeration of pathogenic staphylococci in filterable water as in swimming pools, potable water or spas. It is also used for the detection of Staphylococcus aureus according to the Pharmacopeia and in cosmetic products. | BK030HA – 500 g bottle |

| Model name | Description | Packaging |
|---|---|---|
| Iron Sulfite Agar (TSC Agar Base) | Iron sulfite agar is a media used for the enumeration of sulfite-reducing anaerobes in food microbiology but also in water. The agar base can also be used with Cycloserine for the more specific detection of Clostridium perfringens (refer to the technical data sheet for TSC Agar). | BK031HA – 500 g bottle |
| Meat Liver Glucose Agar with 2 g/L Yeast Extract | Meat Liver Glucose Agar with 2 g/L Yeast Extract is used to enumerate mesophilic and thermophilic anaerobic bacterial spores in raw materials and in ingredients used in canning as well as surface samples and canning process water. | BM16908 – 10 vials of 200 mL |

| Model name | Description | Packaging |
|---|---|---|
| Cetrimide Agar | Cetrimide Agar is a selective medium for the isolation and enumeration of Pseudomonas aeruginosa in biological samples of animal origin and in pharmaceutical and cosmetic products. | BK049HA – 500 g bottle |
| Eugon LT 100 Agar | Eugon LT 100 agar is used for the enumeration of total mesophilic aerobic microorganisms in cosmetic products with or without preservatives. It enables luxuriant colonies to form in the case of most microorganisms. | BK138HA – 500 g bottle |
| Nutrient Agar (2.5%) | Nutrient Agar (2.5%) is used primarily in water microbiology for the culture of microorganisms in the context of purification steps required in certain specific standard or protocols of detection and/or enumeration. Use of this media leads to well isolated colonies. | BM12508 – 50 tubes of 18 mL |
| Plate Count Agar with Skimmed Milk | Plate Count Agar with skimmed milk is used in food and dairy bacteriology to enumerate aerobic bacteria in milk powders and dairy products. It is also used in the enumeration of psychrotrophic microorganisms. | BK161HA – 500 g bottle |
| Plate Count Agar (PCA) | Plate Count Agar containing glucose and yeast extract is used in food bacteriology to enumerate aerobic bacteria in milk, meats, meat-based products, other food products, as well as for the analysis of pharmaceuticals, cosmetics and their associated raw materials. | BK144HA – 500 g bottle BK144GC – 5 kg drum |
| R2A Agar | The R2A (Reasoner’s 2A) agar is a medium destined for the enumeration of total viable aerobic microorganisms in treated water such as purified water, highly purified water and water for injectable preparation. | BK179HA – 500 g bottle |
| Sugar-Free Agar (SFA) | Sugar-Free Agar for the enumeration of contaminants in dairy products is a carbohydrate-free medium used for the detection and enumeration of microorganisms that do not undergo specific fermentation processes during the preparation of dairy products. The result of the enumeration furnishes an indication of the level of contamination of the sample tested. | BK126HA – 500 g bottle |
| Trypto-Casein Soy Agar (TSA) | Trypto Casein-Soy Agar is a universal nutrient medium suitable for a wide range of uses. In light of its excellent nutritive value, it can be used for the growth and isolation of both aerobic and anaerobic bacteria and to favor the development of the most fastidious microorganisms. | BK047HA – 500 g bottle |
| Tryptone-Casein Soy Broth (TSB) | Tryptone-Soy Broth is a universal nutrient medium suitable for a wide range of uses. In light of its excellent nutritive value, it favors the growth of most fastidious microorganisms. It is used in the pharmaceutical industry to satisfy sterility tests and its formula is that listed in the United States Pharmacopoeia for specific and non-specific germs. | BK046HA – 500 g bottle BK046GC – 5 kg drum |
| Yeast Extract Agar | Yeast Extract Agar is used in water microbiology for the enumeration of culturable microorganisms by colony count at 36 and 22°C. The method is intended to measure the functional efficiency of drinking water treatment, and more generally, all types of water. | BK153HA – 500 g bottle |

| Model name | Description | Packaging |
|---|---|---|
| Chloramphenicol Glucose Agar | Chloramphenicol Glucose Agar is destined for the detection and enumeration of yeasts and molds in food products. | BK007HA – 500 g bottle |
| Dichloran Rose Bengal Chloramphenicol Agar | Dichloran Rose Bengal Chloramphenicol agar is recommended for the enumeration of viable yeasts and molds that develop in products destined for human and animal consumption with a water activity (aw) greater than 0.95. | BK198HA – 500 g bottle |
| Dichloran-glycerol (DG-18) Agar | Dichloran-glycerol (DG-18) agar is recommended for the enumeration of yeasts and molds that develop in products with a low water activity (aw less than 0.95). The media finds particular applications for the enumeration and isolation of xerophilic molds which may be found in dehydrated or extremely dry products, such as heavily sugared or salted foods, dried fruits, cereals, cakes and cookies, flour and meat or fish based dehydrated products. | BK170HA – 500 g bottle |
| Oxytetracycline Glucose Agar (OGA) | Oxytetracycline Glucose Agar is used for the detection and enumeration of yeasts and molds in food products. | BK053HA – 500 g bottle BK053GC – 5 kg drum |
| Potato Dextrose Agar (PDA) | Potato Dextrose Agar (PDA) is recommended in standards applied to cosmetic products. It can be used as selective media after addition of chloramphenicol or for applicability trials. This media is also adapted to the growth of yeasts and molds. | BK095HA – 500 g bottle |
| Sabouraud Dextrose Chloramphenicol Agar (SDCA) | Sabouraud Dextrose chloramphenicol Agar (SDCA) is recommended for the isolation and the enumeration of yeasts and molds, especially when the samples are highly contaminated with bacteria. It is also used as selective isolation media for Candida albicans in cosmetic products. | BM17608 – 20 Petri plates Ø 90 mm |
| Symphony Agar | Symphony agar allows the enumeration of yeasts and molds in all human and animal food products regardless of their water activity. It can also be used for the control of environmental samples in production areas. In the case of water samples, they can be analyzed by membrane filtration using this media. | BM20208 – 20 Petri plates Ø 90 mm |
Culture Media Production by BIOKAR Diagnostics
BIOKAR Diagnostics is an industry leader with 50 years of experience in microbiology and we got a chance to visit their factory! Follow Julien Pastor from DKSH Technology and Athanassios Giannakopoulos from BIOKAR to visit this modern factory and learn their production of culture media, from peptones to ready-to-use media.
Key Industries
- Agriculture
- Cosmetics & Personal Care
- Education & Academics
- Environmental
- Food & Beverage
- Medical
- Pharmaceutical
More Products
Biokar Diagnostics is the microbiology division of the Solabia group, dedicated to the development, production and selling of culture media,…